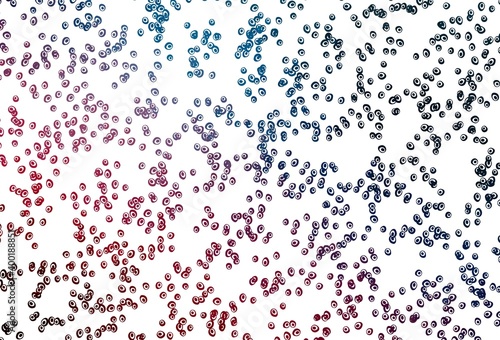

Light Blue, Red vector pattern with spheres.
Keywords
light,
blue,
red,
vector,
background,
low,
blur,
geometric,
pattern,
line,
abstract,
gradient,
graphic,
colours,
blurry,
club,
texture,
design,
circle,
dripped,
round,
bubble,
halftone,
dot,
spot,
lap,
disc,
wheel,
cycle,
sphere,
orb,
page,
paper,
flat,
beam,
flow,
imagination